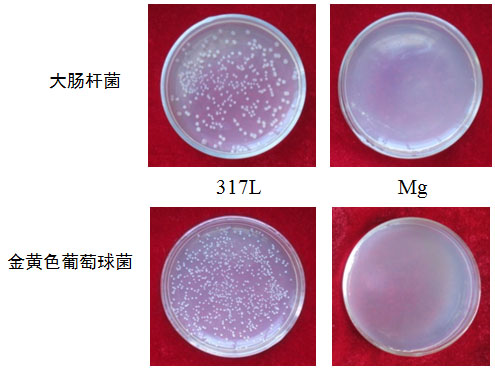

医用金属材料以其高强韧性、耐疲劳、易加工成形性等优良的综合性能,一直是临床上用量最大和应用广泛的一类生物医用材料。医用金属材料是需要承受较高载荷的骨、齿等硬组织以及介入治疗支架的首选植入材料,已大量应用于骨科、齿科、介入治疗等重要医疗领域中的各类植入医疗器械。目前医用金属材料中用量最大、应用范围最广的是不锈钢、钛及钛合金、钴基合金三大类材料,在医用金属材料的生产和临床应用中占有举足轻重的地位。此外还有镍钛形状记忆合金以及金、银、钽、铌、锆等贵金属。
然而,目前临床应用的医用金属材料在生物体中一般表现为生物惰性,不具备生物活性,因此往往需要通过对其进行表面改性,来达到其具备一定生物活性,进而提高其临床使用性能的目的。那么能否使医用金属材料自身就具备某种生物活性呢?至今还未有这方面的研究报道。医用金属材料的生物功能化就是希望解决这一重要问题,因而它是一个具有创新意义和挑战性的新概念,其核心思想就是使医用金属材料在发挥其自身优异力学性能的同时,同时还具备特定的生物医学功能,从而达到更佳的临床医疗效果。杨柯领导的生物材料研究团队近年来进行了多方面的有意义尝试,已经初步实现了特定医用金属材料的生物功能化,并将这一新思想发表在近期的Journal of Materials Science and Technology上(Bio-functional Design for Metal Implants, a New Concept for Development of Metallic Biomaterials, Ling REN, Ke YANG, JMST. 2013, Vol. 29, 1005-1010)。
人们知道,人体中存在有多种不同种类的金属元素,如:宏量金属元素K、Na、Ca、Mg,微量金属元素Fe、Cu、Zn、Mn、Co、Mo、Cr、Sn、V、Ni等,它们在人体中都会发挥不同的生物功能。如果人体中缺失那种金属元素,可能就会引发某种疾病;如果在人体中适量补充某种金属元素,可能会有助于治愈一些疾病。事实上,医用金属材料在人体环境中(无论是体液,还是血液)都会发生不同程度的腐蚀现象,从不锈钢、钛及钛合金、钴基合金等金属材料的极缓慢腐蚀,到目前热点研究的镁基金属的快速腐蚀直至完全降解吸收。因此就可以利用医用金属材料在人体环境中不可避免发生腐蚀的特性,通过特定的合金化设计和制备,在现有医用金属材料中添加某种具有生物医学功能的特定金属元素,利用金属在体内发生腐蚀而造成的这种特定金属元素的持续释放现象,在满足生物安全性的前提下,在实现植入金属力学支撑作用的同时,额外发挥这一特定金属元素的生物医学功能,从而赋予医用金属材料特定的结构/生物医学功能一体化特性。这是一个极富挑战性的创新设想,具有重要的临床应用价值,国际上还未见有人提出相同的思想及相关的研究报道!实现医用金属材料的结构/生物医学功能一体化的关键在于针对临床应用目标的材料设计、制备及性能调控,其应在保持现有同类医用金属材料各项性能水平的基础上,通过特定金属元素的持续溶出,而达到兼有力学承载能力和生物医学功能的双重目的。
在众多金属元素中,铜的生物学作用逐渐得到人们的认可。铜离子是人体中必需的微量金属元素,它的杀菌作用很早就被广泛认可。铜离子对心血管系统具有重要的作用,不仅可以抑制血栓的形成,还能抑制动脉平滑肌的过度增殖、变性等病变,并且能够促进血管内皮再生。近期有医学研究表明,无论是在体外还是在动物体内,Cu2SO4溶液中的铜离子均能明显地促进骨胶原的沉积。由于骨胶原能促进钙、磷等无机物质在骨上的沉积,因而能起到修复骨组织、促进骨再生、改善骨质疏松症状等有益作用。此外,还有医学研究发现,微量铜离子可促进人体组织中的血管化过程,这对人体组织的修复过程具有至关重要的作用。
金属研究所杨柯领导的研究团队近年来研究开发出的系列含铜抗菌不锈钢为上述尝试奠定了材料基础。所谓含铜不锈钢,是指在现有医用不锈钢(304、316L、317L等)的成分基础上,通过加入适度过饱和量的铜元素,经过固溶+时效的热处理,使其基体中均匀弥散地分布有纳米尺度富铜析出相的新型不锈钢。这种含有富铜相的含铜不锈钢在人体环境中由于不可避免地会发生一定的腐蚀,因而可以微量和持续地向周围组织中释放出铜离子,从而发挥出铜离子的诸多有益的生物医学功能。因此,含铜不锈钢巧妙地将不锈钢的优异的力学性能、耐蚀能力与铜离子的生物医学功能相结合。根据医用金属材料生物功能化这一全新的概念,研究团队开展了含铜不锈钢(316L-Cu和317L-Cu)抑制细菌感染、降低支架内再狭窄、促进成骨等生物医学功能的研究探索工作。
图1分别为利用扫描电镜对大肠杆菌和金黄色葡萄球菌在骨科植入常用的317L不锈钢和317L-Cu含铜不锈钢表面上的细菌生物膜形成过程的观察结果。图中大肠杆菌呈杆状,金黄色葡萄球菌呈球状。从图2中可以看到,317L不锈钢的表面上粘附有大量的细菌,并且随着与细菌共培养时间的增加,细菌数量越来越多,形成的细菌生物膜面积和厚度越来越大。当时间达到24h时,可以看到317L不锈钢表面上形成的细菌生物膜已经呈现多层立体结构。然而,317L-Cu不锈钢表面上的细菌数量非常稀少,其随意和零星地分布在不锈钢表面上,而且即使增加与细菌的共培养时间,也没有发现形成细菌生物膜。由此可见,由于含铜不锈钢具有的强烈和广谱杀菌功能,因此能够有效抑制在其表面上形成细菌生物膜。
外科植入物引发的细菌感染是目前亟待解决的重要临床问题,而抗生素的过量使用已经带来了诸多隐患(如使细菌产生抗药性、形成超级细菌等),因此能够从植入物材料入手来降低或抑制细菌感染的发生将具有重要的临床应用价值。临床医学研究表明,在植入物表面形成细菌生物膜是引发细菌感染的主要原因。由以上研究结果可知,由含铜不锈钢制作的外科植入物产品应具有抑制细菌感染的生物医学功能,具有广泛的临床应用前景。在体外实验研究的基础上,将含铜不锈钢制作成骨、齿固定螺钉,蘸上菌液后植入动物体内进行验证。动物植入实验研究结果表明,与普通不锈钢螺钉相比,含铜不锈钢螺钉周围组织中的细菌浓度明显下降,无细菌感染现象发生。在此创新思想指导下,还相继开发出含铜抗菌钛合金、含铜抗菌钴基合金等医用金属新材料。含铜抗菌金属的医学应用属于国际首创,在申报了数项国家发明专利的基础上,研究结果已发表在Journal of Materials Science: Materials in Medicine、Materials Science and Engineering C、Colloids and Surfaces B: Biointerfaces等多个国际相关学术刊物上。目前,研究团队正在与国内相关生产企业合作开发具有抗感染功能的不锈钢骨科、齿科植入物新产品。

图1 317L不锈钢和317L-Cu不锈钢分别与大肠杆菌(E. coli)和金黄色普通球菌(S. aureus)共培养6、12、24小时后,表面形成细菌生物膜的SEM形貌观察。
心血管支架植入是目前治疗冠脉狭窄的一种有效方法,已经得到广泛的临床应用。然而支架植入后引发的冠脉再狭窄现象(称为支架内再狭窄,in-stent restenosis - ISR)是目前临床上亟待解决的重要问题。虽然近年来临床应用的带药支架能够部分地降低ISR的发生率,但其造成的远期再狭窄又是一个新的临床问题。临床研究表明,支架植入后引发的急性血栓以及血管平滑肌的过度增生是ISR发生的二个主要原因,而加快血管内皮化会降低急性血栓的发生。已有医学研究报道,微量铜离子既可降低凝血倾向,有利于抑制血栓形成,又能抑制血管平滑肌细胞(VSMC)的增殖,但促进血管内皮细胞(VEC)的增殖,从而有利于血管的内皮化过程。铜元素的这些影响都会有助于降低ISR的发生率。
316L不锈钢已广泛用于制造心血管支架,如果在316L不锈钢中添加适量铜,而使其在血液环境中微量和持续地释放铜离子,从而发挥铜离子对心血管系统的上述诸多有益作用,就可能从心血管支架用材料方面达到有效降低ISR发生率的目的,这是医用金属材料生物功能化的又一项有意义的尝试。研究团队完成的大量和不同内容(细胞粘附、细胞凋亡、细胞迁移等)的体外研究结果都给予了有利的验证,例如:与316L不锈钢相比,VSMC在316L-Cu含铜不锈钢表面上的粘附量明显降低(见图2(a)),在316L-Cu不锈钢浸提液中的凋亡率增大、迁移能力明显下降,表明含铜不锈钢中的微量铜离子释放具有抑制血管平滑肌的过度增生的生物功能。而与此同时,316L-Cu不锈钢却有助于VEC的增殖(见图2(b)),提高细胞的迁移能力,从而会加快血管的内皮化过程。血小板粘附、动态凝血等实验结果表明,316L-Cu不锈钢具有更优异的抗凝血性能,从而会有利于降低血栓形成倾向。以上体外实验研究结果表明,316L-Cu不锈钢应自身具有降低ISR发生率的生物医学功能,有望成为心血管支架用新一代不锈钢植入材料。目前研究团队已经加工出316L-Cu不锈钢心血管支架,与临床医院合作,正在进行相关的动物植入实验研究。相关研究成果已经申报国家发明专利,并发表在Journal of Materials Science: Materials in Medicine上。

(a)VSMC在不锈钢表面上的形貌

(b)VEC形貌在不锈钢表面上的形貌
图2 VSMC(a)和VEC(b)分别与不同不锈钢共培养24h、72h后,在不锈钢表面上的粘附照片
骨科植入材料通常希望具有良好的与骨组织结合能力,从而实现与骨组织更加牢固的结合。由于现有金属植入材料一般表现为生物惰性,因此往往是通过表面改性来提高其骨结合能力。但由于表面改性涂层材料通常是陶瓷、高分子等非金属材料,涂层与金属基体的结合力往往较差,涂层在使用过程中极易脱落,很难达到预期效果。如果能够赋予金属植入材料表面一定的生物活性,将会具有重要的临床应用价值。近期有医学研究证实,微量的Cu离子能有效地促进骨胶原沉积,并具有促进骨组织中的血管再生功能,因而会有助于成骨过程。因此,以医用金属材料的生物功能化为指导思想,对含铜不锈钢对成骨过程的影响进行了探索性研究,取得了创新性的研究进展。
将小鼠成骨细胞MC3T3 E1分别与317L不锈钢、317L-Cu含铜不锈钢共培养3、7天后发现,在317L-Cu不锈钢表面上的骨细胞伸长明显增大,细胞的平均面积也明显增大,且代表骨细胞增殖能力的碱性磷酸酶(ALP)的表达明显增高,说明骨细胞更适于在含铜不锈钢表面上粘附和生长,反映出含铜不锈钢表面微量释放铜离子的有益生物功能。此外,从Real time-PCR实验结果也看出,多种代表成骨的基因表达显著上调,进一步证明含铜不锈钢应具有促进成骨作用。随后的动物体内植入实验研究结果表明,植入动物骨内15天后,与317L不锈钢相比,317L-Cu不锈钢可明显提高其周围组织的骨密度和骨量,植入物从骨内的推出力明显增大,表明与骨组织的结合力增高。由此可见,含铜不锈钢会明显促进早期成骨过程,表现出一定的表面生物活性,这在现有临床应用的医用金属材料中是从未发现过的。有关上述研究结果已经整理成文章,希望早日刊出发表。
医用金属材料的生物功能化设想的另一有意义的尝试就是生物可降解镁基金属。生物可降解镁基金属(包括纯镁和镁合金)是极具挑战性和革命意义的新型医用金属材料,是近年来医用金属材料的研究热点,在骨科、心血管支架领域中具有重要的应用前景。利用镁基金属在生理环境降解过程中原位产生的高碱性和高的镁离子浓度,以及得到证实的促进成骨作用,研究团队发现了镁基金属植入产生的多种生物医学功能,具有独特的创新性和临床应用价值。研究发现:(1)将镁基金属植入到骨质疏松模型的动物体内后,由于在降解过程中镁离子的原位释放,可明显恢复甚至提高骨质疏松动物骨组织的骨密度,升高其体内的骨形成蛋白(BMP-2)的表达(见图3),因此具有较好的防治局部骨质疏松症的生物功能;(2)镁基金属在降解过程中产生的局部高碱性,具有强烈的抗菌功能(见图4)。将镁植入到骨髓炎模型的动物体内后,可明显抑制细菌的繁殖,具有治疗骨髓炎的潜在应用前景;(3)镁基金属在降解过程中产生的局部高碱性,对多种恶性肿瘤细胞具有较强的杀灭作用,可望防止肿瘤切除后的原位复发,进而在骨肿瘤切除后的骨填充修复中得到临床应用。相关研究结果已经发表在Journal of Biomedical Materials Research: Part A、Materials Letters、Materials Science and Engineering C、Journal of Materials Science: Materials in Medicine、Journal of Materials Science and Technology等期刊上。
利用对人体有益金属元素的适量释放而实现医用金属材料的生物功能化是一项有创新意义、临床应用价值和挑战性的研究方向,其最终目标是使广大患者从中受益,并提高我国相关医疗器械产品的国际市场竞争力。

图3 不同实验组的BMP-2表达,Mg+Os = 在骨质疏松模型大鼠中植入镁合金4周,Control = 正常大鼠对照,Os = 骨质疏松模型大鼠
图4 317L不锈钢和纯镁分别与大肠杆菌、金黄色葡萄球菌共培养后的杀菌效果照片